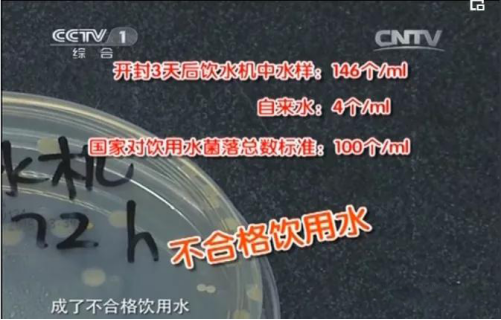

新聞動(dòng)態
水是人身體重要組成部分,人(rén)體有70%以(yǐ)上都是由水構成的。人的一生(shēng)要喝60噸的(de)水。目前為止,飲水機(jī)桶裝水(shuǐ)的方式作為家(jiā)庭、寫(xiě)字樓、學校、醫(yī)院等工作單位解決“喝水(shuǐ)”問題的主(zhǔ)要方(fāng)案之一,在日常生活中我們經常接觸到,那麽飲水機桶裝水(shuǐ)是真的安全(quán)可靠嗎?
重慶市衛生監督局一項(xiàng)調查發現,有超(chāo)過四成家庭從未清洗過飲水機;即使(shǐ)是清(qīng)洗過的家庭(tíng)中,也有高達87%是自己簡單(dān)擦拭,清潔效果有(yǒu)限;這些情況致使飲(yǐn)水(shuǐ)機成為“細菌溫床(chuáng)”,慢慢傷害著人們(men)的健(jiàn)康。

01飲水機桶裝水放久了會怎樣?
央視《生活提示》欄目曾做了一個實驗:分別檢測自來水和桶裝水內的菌落總數,結(jié)果發現,飲水機上的桶裝水開封(fēng)三天,細(xì)菌含量遠高於自(zì)來水。
《生活飲用水標準》GB5749-85規定:每(měi)100m飲(yǐn)用水中的細菌總數不得超過100個,也就(jiù)是說即使是消過毒的飲水機,從3天後接的冷水細(xì)菌數量就開始超標(biāo)了。
在一篇題(tí)為《飲水機菌(jun1)落(luò)總數檢(jiǎn)測及分析》的研究中(zhōng),研究者通過實驗發現第6天的檢測結果菌落總數(shù)最多可能超過1000個,且同(tóng)樣接冷水的情況下(xià),熱水出水口菌落數更多(duō)。

02飲水機桶裝(zhuāng)水中的細菌從(cóng)哪來?
01 空氣中的細菌
空氣中(zhōng)的細菌(jun1)隻有吸附到某個平台後才(cái)會繁殖,而桶裝水與飲水機的交界麵,由(yóu)於空氣濕潤(rùn),剛好給細菌的繁(fán)殖提供了理想環境。桶裝水(shuǐ)裝上飲水機後,每放出(chū)一升水就(jiù)會有相應體積的空氣(qì)進入,而空氣中夾帶各種細菌微生物也隨之附著在飲水機內部(bù)。
02 內膽裏的陳水(shuǐ)
人們喝完水後隻重(chóng)新換上一(yī)桶,忽視了內膽約1000毫升的水,時間長(zhǎng)了,內膽也成了細菌生長的溫(wēn)床。
在未(wèi)經消毒和清洗的情況下,飲水機(jī)使用時(shí)間越長滋生微生物越多(duō)。首都醫科大學的閔嶸醫生介紹說:如果(guǒ)我們喝的水裏有大量細菌的話,會對我們的身體造成巨大的傷害。
所以近幾年(nián)來,越來越多的家庭拋棄了飲水機桶裝水,選(xuǎn)擇管道直飲水作(zuò)為日(rì)常生活飲水方式。那麽他們為什麽選擇管(guǎn)道直飲水?
管道直飲水相比於桶裝水有以下優勢:· 出水新鮮純淨沒有安全隱患,杜絕二次汙染,水(shuǐ)質(zhì)符合(hé)飲用標準。· 飲水便利,想喝就(jiù)喝,很多企業還免費安裝,終(zhōng)身維修,維護成本非常低。· 性價比高,價格低於桶裝水、瓶裝水。
管道直飲水優勢
03飲水品質(zhì)高
江(jiāng)西銀麗管道直飲水采用可循環(huán)封(fēng)閉供水技術,停留時間短(duǎn),不會滋生細菌。可在線上實時監測水(shuǐ)質(zhì),且定期由(yóu)公司專業(yè)人員對設備進行維護,國家權威認證機構CMA定期出具水質檢測報告(gào),保證水質放心飲用。
02安全有保障
同時采用304食品級不鏽鋼管道設立獨(dú)立循環式管(guǎn)網,全天候主管道循環殺菌消毒,循環活水供應,即開即飲,純淨更新鮮。且選用殺菌(jun1)效率高、無有害物殘(cán)留的臭氧消毒模式,結合在線紫外線殺菌作為消毒保鮮工藝,係統管網采用同程全(quán)循環設計,對管道內水源進行無盲端、無死角的定時回流處理,管網(wǎng)中不會存有死水,安全衛生有保障,並且會定期(qī)對管網(wǎng)進行清洗,讓廣大居民可以真正放心地飲用健康直飲水。 管(guǎn)道直飲水是時(shí)代發展的產物,更加符合(hé)當代人的各種需求(qiú),因此(cǐ)管道直飲水代替桶裝水是一種必然趨(qū)勢。
上一(yī)篇:管(guǎn)道直飲水--家庭健康飲水的選(xuǎn)擇
下(xià)一(yī)篇:管道直飲(yǐn)水(shuǐ)真的能解(jiě)決“微汙染水源”問題嗎(ma)?